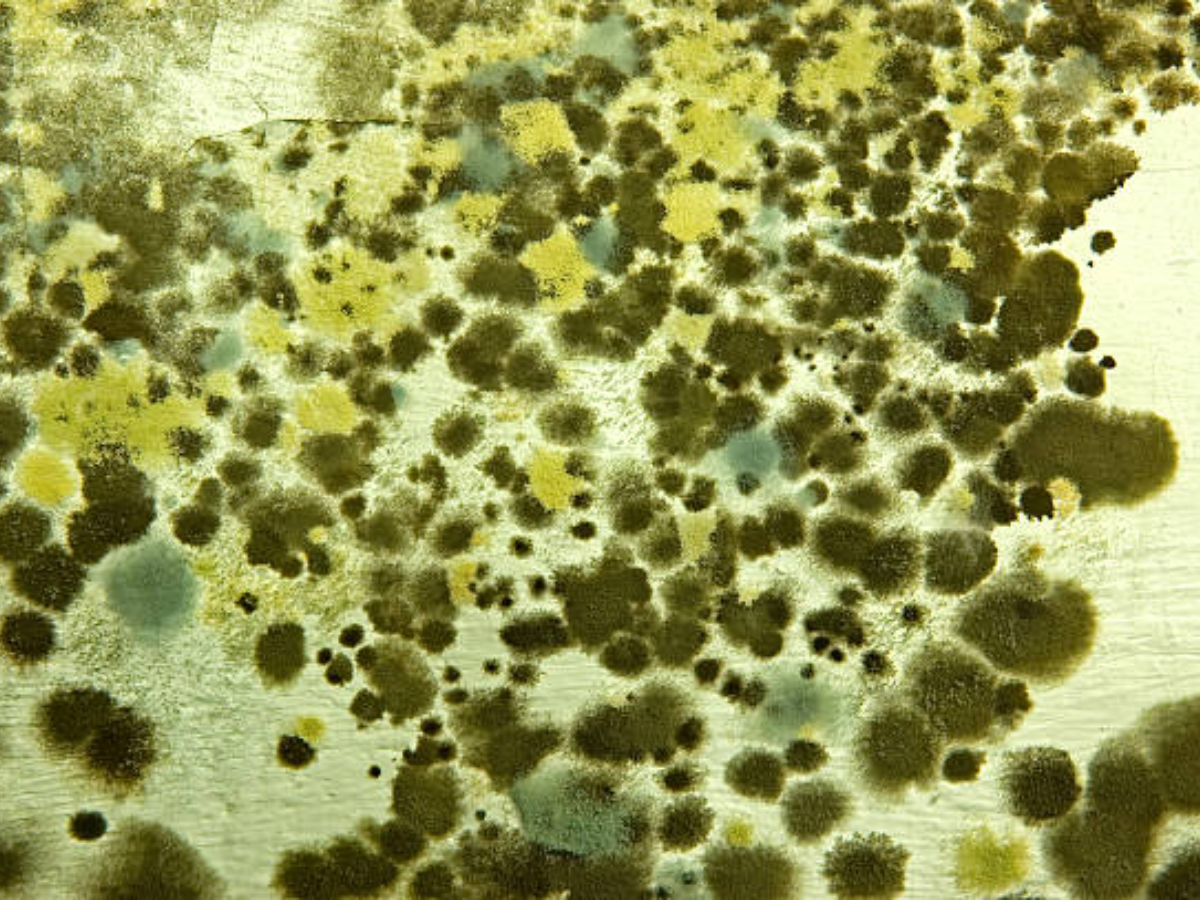

A plant mycologist from India has become the first person in the world to contract a plant fungal disease. The 61 year old, who was diagnosed with the condition in Kolkata, is said to be infected with Chondrostereum purpureum, the fungus that causes silver leaf disease in plants.
Symptoms of the fungal infection
As per a report, the person went to see a doctor after symptoms like hoarse voice, cough, fatigue and difficulties swallowing were seen for three months.
He also had paratracheal abscess in the neck and testing the pus samples revealed the fungal infection. Paratracheal abscess is often accompanied by fever, sore throat, odynophagia, and swelling in the neck down to the hyoid bone.
"He had no history of diabetes, HIV infection, renal or any chronic disease, immunosuppressive drug intake, or trauma. The patient, a plant mycologist by profession was working with decaying material, mushrooms and various plant fungi for a long time as part of his research activities," as per a study published in the Medical Mycology Case Reports says about the symptoms the man had.
As per a media report, the mycologist has recovered after receiving two antifungal medications for two months.
Are fungi infections fatal for human beings?
Studies have found that among the millions of fungi present in the environment only a few hundreds of fungi are able to infect humans and animals.
“Those fungal species that are able to grow at 35–37 °C can become a human pathogen or commensal flora. The pathogen enters the human body through damaged skin and the respiratory tract and can causes infection mostly in immunocompromised individuals,” the study authored by Soma Dutta and Ujjwayini Ray, Consultants, Apollo Multispecialty Hospitals, Kolkata says.
Do cast iron utensils add iron to your food?
Being a mycologist, the person closely works with fungi and this is probably how he caught the infection.
Chondrostereum purpureum is a fungal plant pathogen which mostly attacks the rose family. The fungus has a lethal effect on the plant.
"Silver leaf is a fungal disease of trees caused by the fungal plant pathogen Chondrostereum purpureum. It attacks mostly species of the rose family. The disease is progressive and often fatal. The common name is taken from the progressive silvering of leaves on affected branches. It is spread by airborne spores landing on freshly exposed sapwood. For this reason plants are pruned in summer, when spores are least likely to be present," says the research report.








